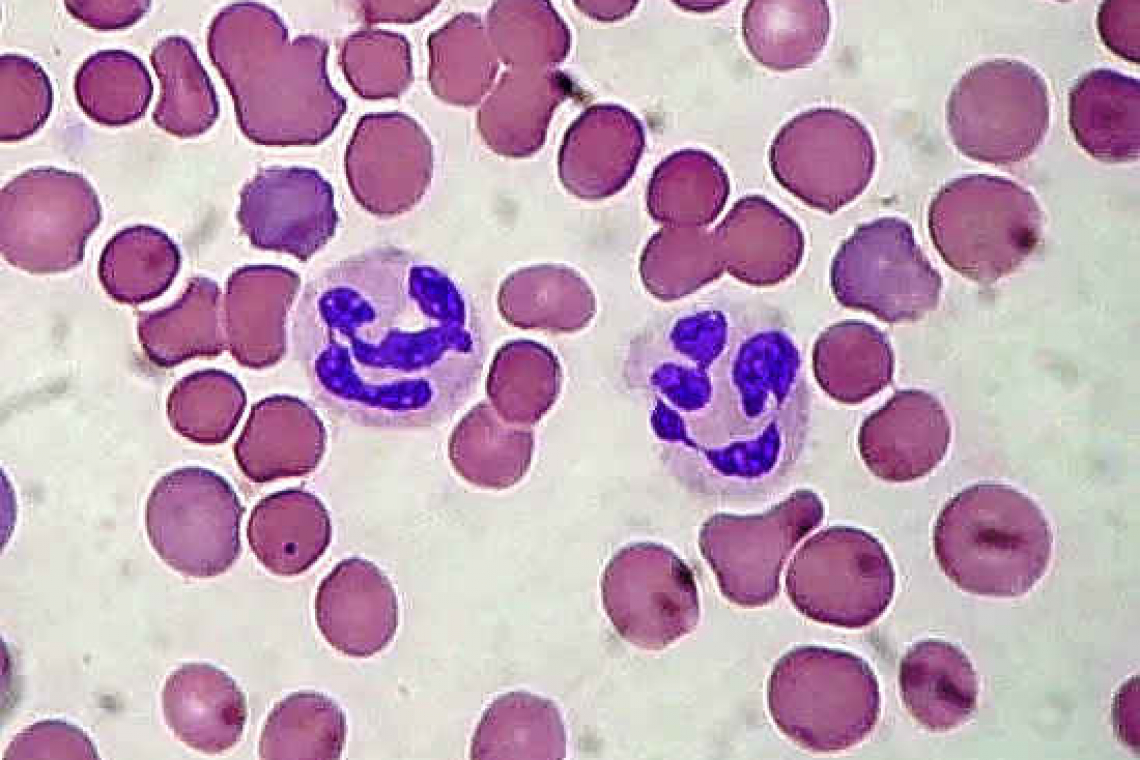

Photo: Two neutrophils among many red blood cells. The normal functions of neutrophils are compromised in chronic granulomatous disease. Image via Encyclopaedia Britannica. GNU Free Documentation License Version 1.2
By Katja Vogt and Colin Michie
“If you have ten times the troops, you should surround the enemy.” - Sun Tzu ‘The Art of War’
Media inform us daily of conflicts around our planet. They record violence, force, damage. Yet, while we take this on board, we are unaware of the hundreds of small skirmishes taking place around our own bodies. Constant frays that leave us unharmed, usually without scars.
Every minute, our immune system takes on potential invasions. A damaged hair follicle on the scalp, nail trauma, a spot on the nose, unhappy cells in the lining of the colon. Our first-line defenders that police these confrontations are single cells called neutrophils. These work to remove bacteria, damaged cells or viral-infected tissues without the collateral chaos of a Marvel comic. We have many of them; they have some remarkable skills and a potent armamentarium. Many millions of them leave our bone marrows each day. They circulate for just a few days before being removed in the spleen, their nutrients recycled. Some move into tissues around the body where they may fight for a longer time and where their activities are more difficult to track.
Younger neutrophils tend to be rounded; they patrol tiny blood vessels by “feeling” capillary linings and sampling the blood they swim in. Should they detect signs of trouble, they become activated, changing shape, extending and wriggling out into the tissues to lead an attack. Damaged or infected cells activate neutrophil defenders by releasing molecular “999” signals or attractants. Neutrophils pour into tissues that release these signals. Once there, they can deploy sophisticated arrays of weaponry. They will move in within hours to clear up dead cells in the brain after a stroke, or muscle cells after a myocardial infarction.
Neutrophils can “eat” invaders of all sorts, enveloping then digesting them internally using toxic enzymes and acids. This process is faster and more effective if the invader is covered with antibody molecules. Vaccines help build up these antibodies, and therefore make it easier for neutrophils to scavenge foreign microbes. For instance, coronavirus vaccines will ensure that neutrophils attack a corona virus infected cell in the eye, nose lung or gut. In some battles with pathogens, neutrophils may eject enzymes to damage a pathogen. They can commit suicide too, squirting their own sticky DNA genes to physically trap a pathogen in a pool of poisonous enzymes – like a cartoon monster show!
These NETs (Neutrophil Extracellular Traps) prevent bacteria from spreading. Most of these processes are microscopic. Dead neutrophils and NETs can be found in the pus from an abscess, your sputum in a chest infection or in diarrhoea in some cases of food poisoning. Your own cells may be damaged, too, in these battles; but more frequently our healing processes direct recovery.
Sometimes, battles against infections deteriorate, often because the bacteria and viruses multiply more rapidly and neutrophil numbers are not large enough to keep up. Those molecular distress signals, when released in large amounts, will cause you to have a fever and feel unwell. Neutrophils can cause swelling or warm, reddened lumps to grow around their war zones. When fighting large battles, neutrophils recruit more neutrophils from the bone marrow. So counting neutrophils in the blood makes it possible to measure your immunological shield.
A full blood count from a blood sample provides numbers and sizes of red cells, as well as types of white cells. High number of neutrophils in this count, in someone with a fever, may indicate that they have an infectious battle that might benefit with some supports. Elevated numbers of neutrophils can also happen in pregnancy, in tobacco smokers, or in those with significant stress – these counts need to be looked at individually.
This numbers game is particularly important for those with low neutrophil counts. If you do not have many neutrophils, how can you keep up with infectious assaults? Many of African descent have low neutrophil counts, or neutropenia, from birth. Although their neutrophil counts are below “normal” levels, these folk are not at an increased risk of infection. More dangerous, however, are low counts that result from chemotherapy or other damage to the bone marrow. In these individuals, infections are more common and more lethal. Antimicrobials or growth factors for the bone marrow are required on occasions to ensure health in those with particularly low neutrophil counts.
These silent and vast armies of tiny gladiators keep going as we work, sleep and play. We can support them with vaccinations. However, there is much yet to be discovered as to how they interact with body tissues, or control their powerful weaponry. Conquering dangerous infection must always be a goal in individuals and communities. Neutrophils are a mysterious part of this that we need to understand better.
Resource:
https://www.cdc.gov/cancer/preventinfections/pdf/neutropenia.pdf